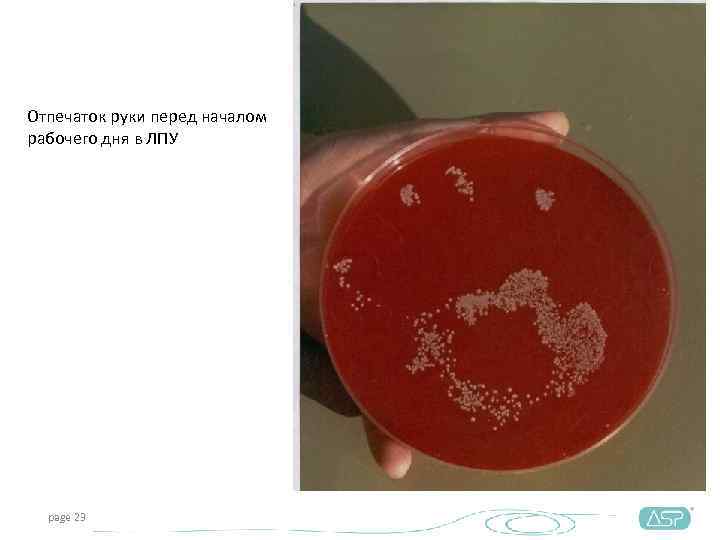
Отпечаток руки перед началом рабочего дня в ЛПУ  page 23
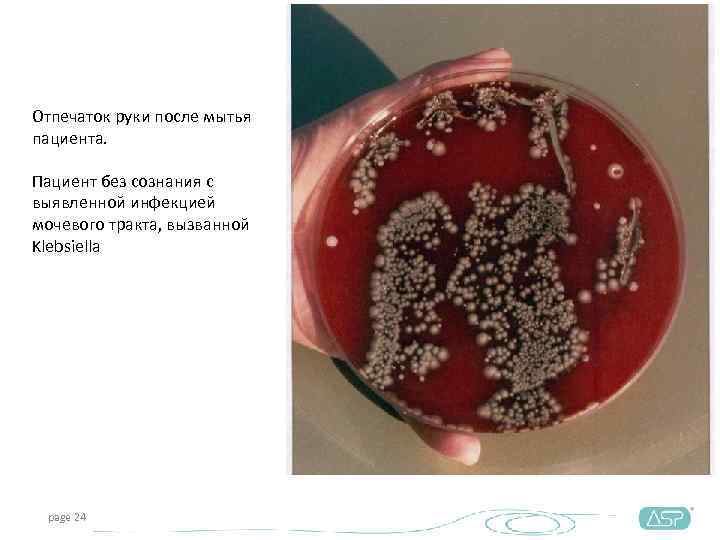
Отпечаток руки после мытья пациента.  Пациент без сознания с выявленной инфекцией мочевого тракта,
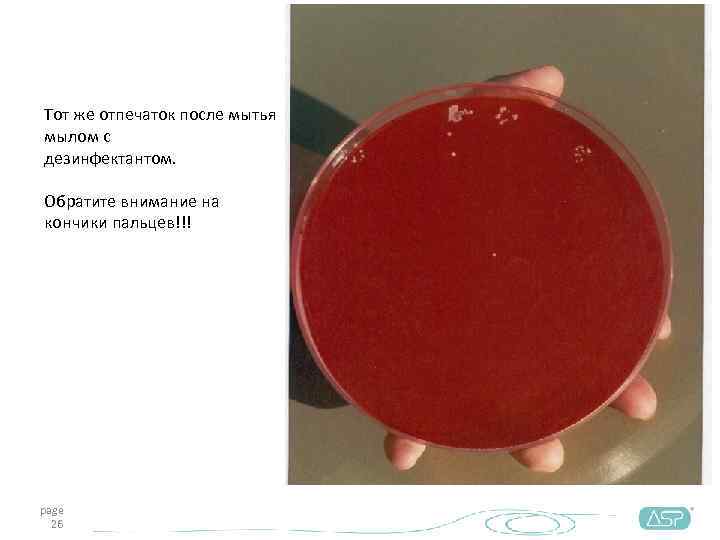
Тот же отпечаток после мытья мылом с дезинфектантом.  Обратите внимание на кончики пальцев!!!

Современные подходы

Современные подходы к обеззараживанию рук медицинского персонала ЛПУ Николаева Валентина, специалист по гигиене рук, ASP Johnson & Johnson 14 декабря 2010
Обеззараживание рук: зачем? • 80%* всех инфекций передается через необеззараженные руки *Данные ВОЗ, 2006 page 2
Они были первыми… 1199 1843 1847 Моисей Маймонид Оливер Уэнделл Холмс Игнац Земмельвейс Рамбам page 3
Сан. Пи. Н 2. 1. 3. 1375 -03 САНПИН 2. 1. 3. 1375 -03 "ГИГИЕНИЧЕСКИЕ ТРЕБОВАНИЯ К РАЗМЕЩЕНИЮ, УСТРОЙСТВУ, ОБОРУДОВАНИЮ И ЭКСПЛУАТАЦИИ БОЛЬНИЦ, РОДИЛЬНЫХ ДОМОВ И ДРУГИХ ЛЕЧЕБНЫХ СТАЦИОНАРОВ « Утвержден: Главный государственный санитарный врач РФ, 06. 2003 11. 7. Врачи, медицинские сестры, акушерки обязаны мыть и дезинфицировать руки перед осмотром каждого больного (роженицы, родильницы) или выполнением процедур, а также после выполнения "грязных процедур" (уборки помещений, смены белья больным, посещения туалета и т. д. ). - при загрязнении рук кровью, сывороткой, выделениями тщательно протирать их тампоном, смоченным кожным антисептиком, после чего мыть проточной водой с мылом. Перчатки обрабатывать салфеткой, смоченной дезинфектантом, затем мыть проточной водой, снимать их и руки мыть и обрабатывать кожным антисептиком;
Сан. Пи. Н 2. 1. 3. 2630 – 10 САНИТАРНО-ЭПИДЕМИОЛОГИЧЕСКИЕ ТРЕБОВАНИЯ К ОРГАНИЗАЦИЯМ, ОСУЩЕСТВЛЯЮЩИМ МЕДИЦИНСКУЮ ДЕЯТЕЛЬНОСТЬ Санитарно-эпидемиологические правила и нормативы Сан. Пи. Н СП 2. 1. 3. 2630 – 10 12. Правила обработки рук медицинского персонала и кожных покровов пациентов (из Главы I, Общие положения) • 12. 9. 1 […]Основными методами обеззараживания рук являются: гигиеническая обработка рук медицинского персонала и обработка рук хирургов. • 12. 4. 1 Гигиеническую обработку рук следует проводить в следующих случаях: • - перед непосредственным контактом с пациентом; • - после контакта с неповрежденной кожей пациента (например, при измерении пульса или артериального давления); • - после контакта с секретами или экскретами организма, слизистыми оболочками, повязками; • - перед выполнением различных манипуляций по уходу за пациентом; • - после контакта с медицинским оборудованием и другими объектами, находящимися в непосредственной близости от пациента. • - после лечения пациентов с гнойными воспалительными процессами, после каждого контакта с загрязненными поверхностями и оборудованием;
Сан. Пи. Н 2. 1. 3. 2630 – 10 САНИТАРНО-ЭПИДЕМИОЛОГИЧЕСКИЕ ТРЕБОВАНИЯ К ОРГАНИЗАЦИЯМ, ОСУЩЕСТВЛЯЮЩИМ МЕДИЦИНСКУЮ ДЕЯТЕЛЬНОСТЬ Санитарно-эпидемиологические правила и нормативы Сан. Пи. Н СП 2. 1. 3. 2630 – 10 Утверждены: постановлением Главного государственного санитарного врача Российской Федерации от 18 мая 2010 г. № 58, ввести в действие с 10. 08. 2010 • 12. 4. 2 Гигиеническая обработка рук проводится двумя способами: • - гигиеническое мытье рук мылом и водой для удаления загрязнений и снижения количества микроорганизмов; • - обработка рук кожным антисептиком для снижения количества микроорганизмов до безопасного уровня. • 12. 4. 3 Для мытья рук применяют жидкое мыло с помощью дозатора (диспенсера). Вытирают руки индивидуальным полотенцем (салфеткой), предпочтительно одноразовым
Сан. Пи. Н 2. 1. 3. 2630 – 10 САНИТАРНО-ЭПИДЕМИОЛОГИЧЕСКИЕ ТРЕБОВАНИЯ К ОРГАНИЗАЦИЯМ, ОСУЩЕСТВЛЯЮЩИМ МЕДИЦИНСКУЮ ДЕЯТЕЛЬНОСТЬ Санитарно-эпидемиологические правила и нормативы Сан. Пи. Н СП 2. 1. 3. 2630 – 10 15. Требования к условиям труда медицинского персонала(из Главы I, Общие положения) • 15. 20 Для ухода за кожей рук использовать смягчающие и защитные кремы, обеспечивающие эластичность и прочность кожи. 3. Основные принципы профилактики внутрибольничных инфекций(из Главы III Профилактика внутрибольничных инфекций в стационарах (отделениях) хирургического профиля 3. 23 Медицинский персонал, имеющий поражения кожи, отстраняется от работы и направляется на обследование и лечение 3. 10 Независимо от использования перчаток, до и после контакта с пациентом, после снятия перчаток и каждый раз после контакта с кровью, биологическими жидкостями, секретами, выделениями или потенциально контаминированными предметами и оборудованием, проводится гигиеническая обработка рук.
Исследование Euridiki ия Причин ы невыполнен к требований по обработке ру 61% неудобство/забывчивость 42% недостаток информации и знаний 35% недостаток времени 22% проблемная кожа 17% нет мотивации Если бы возбудители ВБИ выглядели так? ? ? Larson and Killien , AJIC 1982; 10: 93 Dubbert et al. , ICHE 1990; 11: 191 Zimakoff et al. AJIC 1992; 20: 58 Conly et al. AJIC 1989; 17: 330 Sproat and Inglis, JHI 1994; 26: 137 Larson and Kretzer, JHI 1995; 30: 88 Pittet et al. Annals Intern Med 1999; 130: 126 Kretzer and Larson, AJIC 1998; 26: 245 page 8
Причины невыполнения рекомендаций – недостаток времени Мытье рук Подойти к раковине (если она в пешей доступности. . ) - Высушить руки полотенцем - Открыть воду на (рекомендовано одноразовым) несколько секунд - Ополоснуть руки и - Смочить руки и запястья запястья - Намылить руки и запястья 10 -15 - Выдавить порцию мыла/взять секунд мыло и смочить его = 1 – 2 минуты page 9
Решение проблемы Безводная гигиеническая обработка - выдавить 3 мл средства из диспенсера, расположенного у места осмотра/манипуляции - Втирать средство в течение 30 секунд = 35 секунд Наличие дезинфектанта – более высокое качество обработки page 10
Причины невыполнения рекомендаций – заболевания кожи рук. Как работа в ЛПУ влияет на состояние кожи? • Частое мытье может привести к сухости кожи рук • Неправильные методики или средства для мытья – самая частая причина профессиональных дерматитов • Ношение перчаток может повышать чувствительность к латексу и другим компонентам page 11
Чаще уверены антисептик мыло антисептик На самом деле
Мытье рук – одна из причин контактного дерматита у мед. работников Мыла снижают барьерную функцию кожи, изменяют структуру протеинов продолжительный контакт с мылом вызывает повышение р. Н до 7, 0 -8, 5 Моющие средства растворяют жир 1) естественный кожный жир Вода смывает жидкие кожные 2) поверхность кожи липиды с рогового слоя 3) вода гидролипидного слоя
Микрофлора кожи ТРАНЗИТОРНАЯ МИКРОФЛОРА Роговой слой канал РЕЗИДЕНТНАЯ МИКРОФЛОРА Волосяной Сальная фолликул железа ГИГИЕНИЧЕСКАЯ ОБРАБОТКА ХИРУРГИЧЕСКАЯ ОБРАБОТКА
Микрофлора кожи • Резидентная микрофлора микроорганизмы, в норме находящиеся на коже, живущие и размножающиеся на ней • Транзиторная микрофлора условно патогенные и патогенные микроорганизмы ü Резистентные организмы бактерии, устойчивые к антибиотикам - MRSA, VRE. page 15
Иерархия микроорганизмов Классификация по степени Бактериальные сложности уничтожения: споры Микобак от сложного к простому терии Вирусы без оболочки Clostridium Sporogenes Грибы Вегетативные Micobacterium формы tuberculosis Rotavirus бактерий Оболочечные Candida вирусы MRSA page 16 HIV (ВИЧ)
Здоровая кожа обладает механизмом защиты от инфекций • Эпидермис – физический барьер для микроорганизмов • кислый p. H (5. 5) кожи подавляет рост многих микроорганизмов • Кожа насыщена капиллярами, позволяющими быстро доставлять лейкоциты и другие вещества, необходимые для иммунного ответа page 17
Последствия нарушения целостности кожи • Патогенные микроорганизмы проникают в подкожную клетчатку • Становится трудно смыть микроорганизмы • Внутрибольничные инфекции (ВБИ) ВБИ - любое клинически распознаваемое инфекционное заболевание, которое поражает больного в результате его поступления в больницу или обращения за лечебной помощью, или инфекционное заболевание сотрудника больницы вследствие его работы в данном учреждении вне зависимости от появления симптомов заболевания до или во время пребывания в больнице. page 18
Последствия ВБИ Для ЛПУ: • дополнительное время госпитализации • лечение антибиотиками • временные затраты персонала Для общества: • потребность в дополнительной квалифицированной помощи • растет число дней нетрудоспособности Американские исследования доказывают, что 1 USD, вложенный в профилактику ВБИ, в конечном счете сэкономит 10 USD. Медицинская газета № 73 — 20 сентября, ВБИ: на бумаге одно, а в больнице. . . Интервью с Г. Г. Онищенко page 19
Дифференцированный подход к обработке рук определение: “Мытье''. . . удаление внешних загрязнений и создание впечатления чистоты определение: “Дезинфекция''. . . снижение числа микроорганизмов до степени, в которой передача инфекции исключена. page 20
Три уровня обработки (деконтаминации) рук: Удаление или уничтожение транзиторной микрофлоры и снижение численности резидентной флоры Удаление или уничтожение транзиторной микрофлоры Хирургич еская Удаление грязи и антисепт ика транзиторной микрофлоры Гигиеничес кая антисептик а Обычное мытье рук
Пример
Отпечаток руки перед началом рабочего дня в ЛПУ page 23
Отпечаток руки после мытья пациента. Пациент без сознания с выявленной инфекцией мочевого тракта, вызванной Klebsiella page 24
Тот же отпечаток после мытья рук обычным мылом. Транзиторная патогенная флора сохраняется. page 25
Тот же отпечаток после мытья мылом с дезинфектантом. Обратите внимание на кончики пальцев!!! page 26
Проблемные зоны Основная масса бактерий скапливается на кончиках пальцев Кончики пальцев и большие пальцы наиболее часто вступают в контакт с пациентом и потенциально загрязненными поверхностями
Что можно сделать для профилактики ВБИ? • ГИГИЕНА РУК • Простейший и важнейший путь снижения ВБИ • Мытье рук согласно нормативам page 28
Частота внутрибольничной колонизации и инфекции пациентов отделения реанимации новорожденных после мероприятий по улучшению качества гигиены рук
Гигиеническая обработка рук ШАГ 1 Положить ладонь на ладонь ШАГ 2 Круговыми движениями тереть кончики пальцев о ладонь другой руки * page 30
Гигиеническая обработка рук ШАГ 3 Правой ладонью накрыть левую ШАГ 4 Ладонь на ладони с расставленными и перекрещенными пальцами page 31
Гигиеническая обработка рук ШАГ 5 Внешние части фаланг пальцев об ладони рук с перекрестом пальцев ШАГ 6 Круговым движением тереть большие пальцы ладонью другой руки page 32
Основные условия для качественного обеззараживания рук • коротко подстриженные ногти • отсутствие лака на ногтях • отсутствие искусственных ногтей • отсутствие на руках колец, часов, браслетов и других ювелирных украшений • использование чистых тканевых полотенец / одноразовых бумажных салфеток, при обработке рук хирургов- ТОЛЬКО СТЕРИЛЬНЫХ САЛФЕТОК! Сан. Пи. Н 2. 1. 3. 2630 -10
« 5 случаев обработки рук»
Дезинфекция рук и перчатки Дезинфекция рук необходима: ПЕРЕД ПОСЛЕ НАДЕВАНИЕМ СНЯТИЯ ПЕРЧАТОК! page 35
Дезинфекция рук и перчатки page 36
Перчатки – гарантия защиты? ? ? ü 53 -80% перчаток повреждается при операции ü врач/медсестра замечает повреждения в 15 -20% случаев ü жидкость проникает в перчатки – от 9% (латексные) до 32% (виниловые) ü «физиологические» отверстия в перчатках * Рекомендации Сан. Пин (ДОПОЛНЕНИЕ N 1 К САНПИН 2. 1. 3. 1375 -03)
Дезинфекция рук и перчатки Новые брендированные виниловые перчатки, не стерильные, верхушка указательного пальца Photo: K. -P. Wefers, Zentrum für Zahn-, Mund- und Kieferheilkunde der Universität Gießen page 38
Дезинфекция рук и перчатки Новые брендированные виниловые перчатки, не стерильные, ладонь Photo: K. -P. Wefers, Zentrum für Zahn-, Mund- und Kieferheilkunde der Universität Gießen page 39
Дезинфекция рук и перчатки „маленькое“ отверстие в перчатке имеет размер 5000 нм (10 -9 м)! Вирус оспы 120 - 320 nm аденовирус 70 - 80 nm Вирус герпеса Polymona-вирус 150 - 250 nm 44 - 55 nm Вирус паротита 120 - 150 nm вирус гепатита B 40 - 45 nm Вирус гриппа 120 - 150 nm Вирус полиомиелита Вирус гепатита 25 nm 100 - 120 nm page 40
Можно ли обрабатывать одноразовые перчатки при переходе от пациента к пациенту? Не рекомендуется, потому что вызывает: ü повышение проницаемости ü сохранение микрофлоры в «порах» перчаток ü увеличение срока ношения перчаток приводит к накоплению «перчаточного сока» , содержащего большое количество микроорганизмов
Проницаемость перчаток • 20, 9 ± 3, 2 – не обрабатывали антисептиком • 34, 1 ± 4, 2 – один раз обрабатывали антисептиком • 40, 9 ± 3, 7 – более 5 раз обрабатывали антисептиком Зуева Н. П. , кафедра эпидемиологии Пермского государственного медицинского университета, 2010 г.
Обзор современных средств антисептической обработки рук
Действующие вещества (ДВ): основные характеристики Критерии оценки ДВ: ü Спектр антимикробной активности M. Tuberculo Грам (+) Грам (-) Грибы Вирусы Споры sis ü Скорость действия ü Влияние на кожу рук ü Вероятность формирования резистентности page 44
Действующие вещества: спирты Спектр антимикробной активности Максимальный для кожных антисептиков M. Tubercul Грам (+) Грам (-) Грибы Вирусы Споры osis +++ +++ - Оптимальная концентрация 60 -95% Скорость действия Быстрое • не вызывают аллергии, • не токсичны Влияние на кожу рук • при наличии смягчающих добавок не сушат кожу Эффект пролонгации Нет Резистентность Нет page 45
Этиловый и изопропиловые спирты: особенности Этиловый спирт Пропиловые спирты Наименее цитотоксичен Большая бактерицидная Наименее раздражающее действие активность Наибольшая активность против безоболочечных вирусов (особенно n-пропанол = 1 - пропанол) *безоболочечные вирусы – ротавирус, энтеровирус, аденовирус и др. page 46
Обработка первомуром (надмуравьиной кислотой) Первомур - смесь муравьиной кислоты, перекиси водорода и воды. Используется 2, 4 % раствор, приготовленный ex temporo. Методика: мытье рук производится в тазах в течение 1 минуты, руки высушиваются стерильной салфеткой. Преимущество метода - быстрота. Недостатки: развитие дерматита на руках хирурга раствор требует приготовления (человеческий фактор, дополнительные временные затраты на приготовление) использование тазов – дополнительный риск контаминации
Действующие вещества: триклозан Спектр антимикробной активности Не полный M. Tubercul Грам (+) Грам (-) Грибы Вирусы Споры osis +++ + - +++ - Скорость действия Постепенное Влияние на кожу рук Аллергия/ раздражение - редко Резистентность Да page 48
Действующие вещества: ЧАС Спектр антимикробной активности Не полный M. Tubercul Грам (+) Грам (-) Грибы Вирусы Споры osis + ++ - - + - Скорость действия Медленное Влияние на кожу рук Вызывает сухость кожи Резистентность Средний потенциал Предпочтителен: низких концентрациях в средствах для хирургической дезинфекции в page 49
Действующие вещества: хлоргексидин Спектр антимикробной активности Не полный M. Tubercul Грам (+) Грам (-) Грибы Вирусы Споры osis +++ + + +++ - Скорость действия Постепенное Может вызывать аллергию в Влияние на кожу рук высокой концентрации (2 -4%) Резистентность Средний потенциал Предпочтителен: низких концентрациях (~0, 5%) в комбинации с этанолом (усиливает его действие) в средствах для хирургической дезинфекции в page 50
Комбинация – эффект синергии Более широкий спектр антимикробного действия Повышенная эффективность Бактерицидные свойства Пропанол-1 + Пропанол-2 Вирулицидные свойства Этанол + Хлоргексидин
Эффект пролонгации: хорошо или плохо? Гигиеническая обработка рук Обработка рук хирурга «-» «+» Подавляет размножение не только Во время операции микрофлора не транзиторной (патогенной), но и размножается под перчатками резидентной флоры Защитный барьер кожи не восстанавливается
Алгоритм выбора кожного антисептика Обычное мытье Гигиеническое мытье Постоянный уход Моющий лосьон с Моющий лосьон антимикробным эффектом Гигиеническая обработка Обработка рук хирурга без воды Крем или лосьон Антисептик широкого Антисептик с спектра действия: пролонгированным раствор или гель действием
Спиртосодержащие кожные антисептики для обработки рук ТЕХНИКА • Убедитесь, что на руках нет видимых загрязнений (кровь, слизь и др. ) • Нанесите продукт на ладонь одной руки и потрите руки друг об друга, равномерно распределяя средство по всей поверхности рук • Убедитесь, что продукт проникает во все зоны • Дайте рукам высохнуть • Процесс должен занимать примерно 30 секунд (в зависимости от инструкции по применению) • CDC recommendations of practice: MMWR) page 54
«Идеальный» кожный антисептик. Каким он должен быть? Критерии: • Широкий спектр действия • Быстрый эффект • Последействие (для хирургической обработки) • Без аллергии и раздражения кожи • Хорошие потребительские свойства page 55
MICROSHIELD® портфель продуктов
Продукция для гигиены рук Мытье и уход Гигиеническое мытье рук Гигиеническая и Обработка кожи хирургическая обработка пациента
Мытье и уход • Специально для ЛПУ • Помогает поддерживать барьерную функцию кожи • Для работника ЛПУ и пациента Lanoskin® Lanosoap® Легкий и нежный Нежный моющий увлажняющий лосьон лосьон для кожи рук и тела Подходит даже для детей и пожилых людей. Для частого мытья: оптимальное значение p. H и смягчающие добавки page 58
Гигиеническое мытье рук • Эффективен: бактерии (в т. ч. MRSA, M. Tuberculosis), грибы(C. albicans), вирусы (вкл. ВИЧ, гепатит B и C). • Не содержит щелочей • Не вызывает раздражения кожи Lanosoap® Des Комбинированный эффект мытья и дезинфекции 1 -пропанол -10% 2 -пропанол – 8% 2 -бифенилол – 2% page 59
Гигиеническая обработка рук. Обработка рук хирурга. • Высокоэффективны: бактерии (в т. ч. MRSA, M. Tuberculosis), грибы(C. albicans), вирусы (вкл. ВИЧ, гепатит B и C) • Содержат ингредиенты, увлажняющие и питающие кожу • Комбинированный продукт => повышенная эффективность Dodeman® Extra Gel Этанол – 20% Пропанол-1 – 25% Этанол – 78, 2 % Пропанол-1 – 27, 6 % Пропанол -2 – 27% Пропанол-2 – 10% Пропанол -2 – 36, 1 % Хлоргексидин – 0, 5% 2 -бифенилол – 0, 1% page 60
Обработка кожи пациента • Высокоэффективны: бактерии (в т. ч. MRSA, M. Tuberculosis), грибы(C. albicans), вирусы (вкл. ВИЧ, гепатит B и C) • Комбинированный продукт Dodesept® T Dodesept® C Бесцветный Окрашенный Этанол – 20% Этанол – 25% Пропанол-1 – 30% Пропанол-1 – 45% Пропанол -2 – 25% 2 -бифенилол – 0, 1% page 61
J&J отвечает на требования специалистов Общие свойства продукции Содержат увлажнители и другие Высоко эффективны компоненты, защищающие кожу Подходят для частого применения Включают «карманную» форму Соответствуют последним антисептика рекомендациям ВОЗ Комбинированный продукт => улучшенный бактерицидный и Десятки лет вирулицидный эффект безопасного использования
Ступенчатый подход ASP J&J к гигиене и дезинфекции рук Dodeman® Extra Dodeman® Gel Dodeman ® Dodesept® C Dodesept ® T Lanosoap Des ® Dodeman Gel ® Dodeman ® Lanosoap® Хирургическая Lanoskin ® антисептика Гигиеническая Обычное мытье рук антисептика
Продукция Microshield®: фильм page 64
СПАСИБО ЗА ВНИМАНИЕ! ПЕРЕХОДИМ К ПРАКТИЧЕСКОЙ ЧАСТИ
ПРАКТИЧЕСКАЯ ЧАСТЬ page 66

